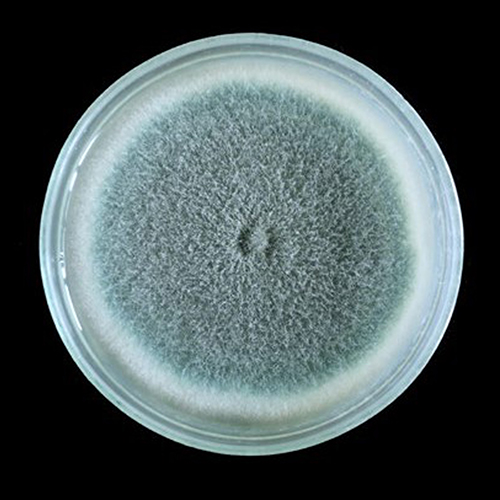
fungus Aspergillus Flavus

Below are sample translational research stories that illustrate how the framework can be used to demonstrate the evolution of an idea through the various translational research categories.

Uncovering Targets to Treat Pain and Chronic Diseases
From insect hormones to human health, NIEHS-funded research decodes the biology behind environmental risk, pain, and organ damage — and how to intervene.

Finding the Genetic Causes of Lupus
NIEHS-supported research is shedding light on how mutations in genes controlling DNA repair may drive autoimmune disorders.

New Tools for Preventing and Treating Uterine Fibroids
NIEHS-funded scientists are uncovering risk factors for uterine fibroids and developing interventions to help the populations most affected.

Protecting Coastal Communities from Ocean Risks
National Institute of Environmental Health Sciences (NIEHS)-funded researchers are helping communities understand and respond to health risks from ocean pollutants, including harmful algal blooms (HABs).

Addressing Environmental Exposures and Autism
The National Institute of Environmental Health Sciences (NIEHS) supports research exploring how early-life environmental exposures may interact with genetic factors to influence brain development and contribute to autism spectrum disorder (ASD). ASD is a neurodevelopmental condition that affects communication, learning, behavior, and social interactions.

Promoting Safer Fish Consumption
Supported in part by the National Institute of Environmental Health Sciences (NIEHS) Superfund Research Program (SRP), and with strong community partnerships, researchers helped improve fish consumption advisories and created awareness campaigns to educate subsistence fishers about contaminants in fish.
Unraveling How a Natural Toxin Contributes to Liver Cancer
The National Institute of Environmental Health Sciences (NIEHS) has supported decades of research on aflatoxin, a harmful compound produced by certain fungi. People can accidentally consume aflatoxin by eating tainted corn, peanuts, and some grains. Risk of exposure is greater in regions where food safety is not or cannot be enforced.

Addressing Childhood Asthma in Rural Agricultural Communities
The National Institute of Environmental Health Sciences (NIEHS) supported a study that may lead to improved health for children suffering from asthma. Asthma is a serious respiratory disease that affects about 6 million children in the U.S., causing wheezing, difficulty breathing, and coughing.

Protecting Arctic Communities
Alaska Community Action on Toxics researchers work with tribal members, health care professionals, students, teachers, and scientists to conduct community-based participatory research that has revealed the extent of contamination in the island and associated health effects.

Protecting Farmworkers and Families From Pesticide Exposure
NIEHS funds researchers to work with agricultural communities to prevent exposure to organophosphate pesticides, which are commonly used in commercial agriculture to control insects.
- Protecting Farmworkers and Families From Pesticide Exposure (1MB)
- Timeline for Protecting Farmworkers and Families From Pesticide Exposure (718KB)
- Reference List - Protecting Farmworkers and Families From Pesticide Exposure (85KB)

Protecting the Health of Mothers and Babies
Funded by NIEHS Superfund Research Program (SRP), a team of researchers studies environmental exposures that lead to high rates of preterm birth, and other adverse health outcomes, among mothers and their babies in Puerto Rico. The program is called Puerto Rico Test Site to Explore Contamination Threats (PROTECT).
- Protecting the Health of Mothers and Babies (1MB)
- Timeline for Protecting the Health of Mothers and Babies (891KB)
- Reference List - Protecting the Health of Mothers and Babies (455KB)

Reducing PFAS in Drinking Water
NIEHS funds researchers to work with communities to identify sources of exposure to harmful chemicals like per- and polyfluoroalkyl substances (PFAS) and to prevent these exposures.
- Reducing PFAS in Drinking Water (1MB)
- Timeline for Reducing PFAS in Drinking Water (695KB)
- Reference List - Reducing PFAS in Drinking Water (115KB)

Understanding Pesticide Toxicity
Exposure to a group of pesticides called organophosphates can contribute to neurodevelopmental problems, among other health challenges. Since 1989, the National Institute of Environmental Health Sciences (NIEHS) has supported research into the role of a gene called PON1, which helps protect people from the harmful effects of organophosphate exposure.
- Understanding Pesticide Toxicity (1MB)
- Timeline for Understanding Pesticide Toxicity (860KB)
- Reference List - Understanding Pesticide Toxicity (76KB)


